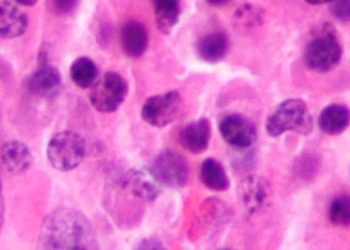
Adding daratumumab increases progression free survival in multiple myeloma

Chimeric antigen receptor T-cell therapy may induce sustained remission in multirefractory autoimmune hemolytic anemia
1. In this prospective cohort study, CD19-directed chimeric antigen receptor (CAR) T-cell therapy was found to elicit a complete response ...